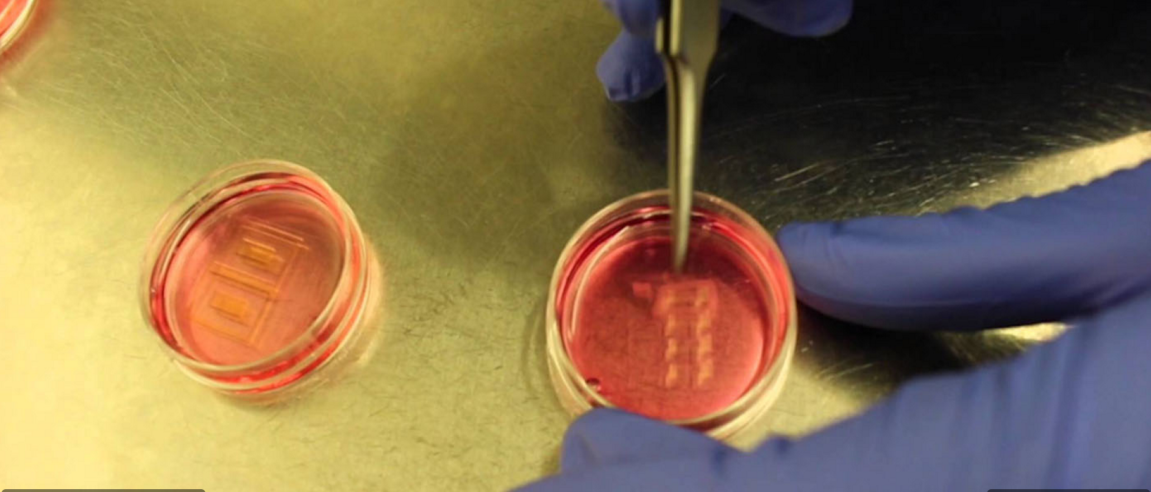

A New Kind of Robot
Meet the bio-bots—they’re small, twitchy hybrids of muscle tissue and algal cells that seek out light like moths to a flame.
And they’re really, really cool.
The new “machines” were designed by a team from the University of Illinois, led by Rashid Bashir, and the paper describing their effort has been published in the Proceedings of the National Academy of Sciences.
The concept underlying these new biological robots is simple, but the potential applications—in just about every field of endeavor where robotics may have a role—are myriad. Bashir and his team “built” (maybe “grew” is a better word) their bio-bots by first culturing rings of muscle tissue from a mouse-derived line of cells; these GM muscle cells, however, possessed engineered algae genes which made them sensitive to blue light.

Optogenetic Biological Robots
It’s a technique called “optogenetics,” and this essentially novel mélange of eukaryotic tissues responds to the stimulus of blue light by contracting its muscle cells. The muscle rings were layered around flexible, 3D-printed “vertebrae,” whose maximal shape and configuration were arrived at by the team through a process of trial and error.
The researchers even exercised the bio-bots daily with flashing blue lights, training and conditioning the tissue so it would be stronger and capable of greater movement and flexibility.
According to Bashir, the new design and the non-invasive optogenetic techniques represent a vast improvement over previous biological robots.
“With the rings, we can connect any two joints or hinges on the 3-D-printed skeleton. We can have multiple legs and multiple rings. With the light, we can control which direction things move. People can now use this to build higher-order systems.”
What these “higher-order systems” might constitute can be left to the reader’s imagination, but it requires no great leap to envision the multiple applications of a robotic technology that employs light-activated living tissue.
It seems robotics has finally seen the light.
